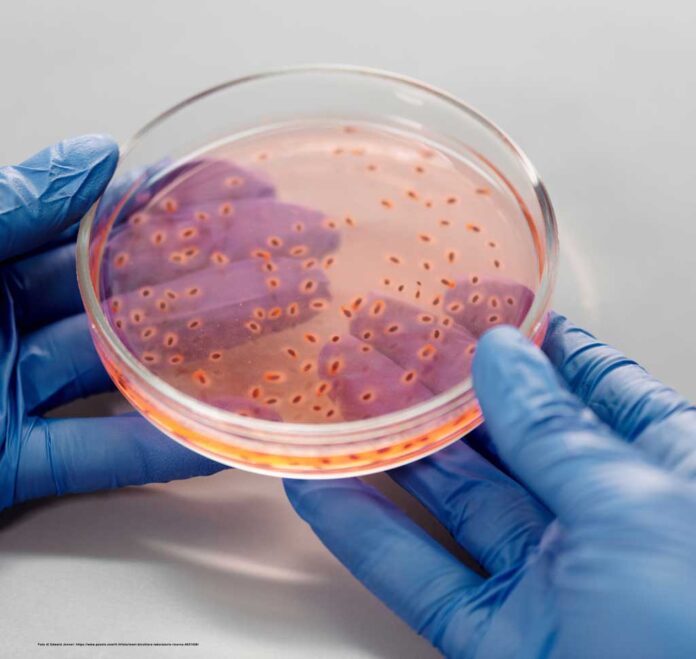
candida-auris

Candida Auris è un emergente tipo di Candida che ha caratteri peculiari che la differenziano da altre forme micotiche e rappresenta una seria minaccia per la salute globale.
Può sopravvivere sulla cute anche per mesi in modo asintomatico ed è più resistente agli agenti antifungini rispetto ad altre specie di Candida (multifarmaco-resistenza); si diffonde nelle strutture sanitarie e viaggia facilmente da paziente a paziente o da una superficie contaminata (es maniglia di una porta) al paziente; è di difficile identificazione nei laboratori che non dispongono di tecnologie specifiche, con conseguente gestione inappropriata.
Agisce come un killer furtivo e nella forma invasiva può portare a serie infezioni del sangue, cuore e altre parti dell’organismo con una mortalità in pazienti con altre comorbidità, superiore al 60%.
Isolato ufficialmente la prima volta nel 2009 in Giappone nell’orecchio di una donna – donde il nome Candida auris – questo fungo è ora presente, secondo l’OMS, in 55 paesi.
Sottovalutato per lungo tempo, nell’ ottobre 2022 l’WHO ha inserito C Auris fra i 4 patogeni fungini più critici insieme a Cryptococcus neoformans, Aspergillus fumigatus, e Candida albicans.
Vi sono evidenze che il cambiamento climatico sta influenzando l’ecologia dei patogeni fungini espandendo il loro habitats e che la popolazione a rischio di infezioni serie da Candida Auris ed altri patogeni fungini è in aumento, in quanto gli individui immunocompromessi (pazienti con HIV – Tubercolosi – Cancro trattato con chemioterapia, trapiantati renali etc.) vivono oggi comunque più a lungo.
Anche durante la pandemia da COVID- 19 l’incidenza di infezioni da Candida Auris è aumentata, specialmente nelle Terapie intensive con l’utilizzo dei ventilatori.
Sottovalutare queste infezioni fungine non aiuta.
C. auris è stato isolato da una serie di siti corporei, tra cui la pelle (molto comune), il tratto urogenitale (comune) e il tratto respiratorio (occasionale), e provoca più raramente infezioni invasive, come candidemia, pericardite, infezioni del tratto urinario e polmonite.
I più comuni segni di infezione invasiva da Candida sono febbre e brivido che non rispondono agli antibiotici.
La colonizzazione da C. Auris è spesso associata ad una sovrainfezione con batteri gram negativi produttori di carbapenemase.
La prevenzione della diffusione della infezione si ottiene effettuando tamponi a livello ascellare o inguinale alla ricerca del fungo.
Sono necessari particolari test di laboratorio per la corretta identificazione.
Gli strumenti diagnostici basati sulla tecnologia MALDI-TOF (Matrix Assisted Desorption Ionization – Time Of Flight) sono in grado di distinguere C. auris dalle altre Candida spp., ma non tutti i database di riferimento degli spettrometri MALDI-TOF includono questa specie.
Pazienti già colonizzati o infettati devono essere ricoverati in stanza singola e tutti i visitatori e il personale di assistenza devono osservare la corretta igiene delle mani (con acqua e sapone o soluzione idroalcolica o clorexidina), indossare camice e guanti monouso, assicurare la decontaminazione delle apparecchiature e dei dispositivi utilizzati da altri pazienti.
La persistenza della Candida Auris dura anche oltre un anno dalla sua identificazione e sembra trarre vantaggio dal danneggiamento del microbioma cutaneo causato da cure antibiotiche protratte.
Negli USA circa il 30% di colonie di C Auris isolate sono risultate resistenti alla a amphotericina B, circa il 90% al fluconazolo, e meno del 5% erano resistenti alla nuova classe di farmaci antifungini echinocandine.
In alcuni casi la resistenza era a tutte e tre le classi di antifungini. Nuovi farmaci antifungini sperimentati recentemente (ibrexafungerp) hanno dimostrato buona attività.
BIBLIOGRAFIA
Rita Rubin. On the Rise, Candida auris Outwits Treatments and Travels Incognito in Health Care Settings JAMA. 2023;329(3):197-199. doi:10.1001/jama.2022.17760
Candida auris . Epicentro Istituto superiore di Sanità www.epicentro iss.it